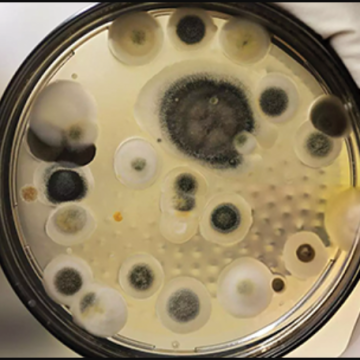

The following story was reported by The Utah Investigative Journalism Project in partnership with Utah Stories. The trek into the office is a necessary evil for many employees; it’s unpaid time that could be spent elsewhere. But some state employees are able to cash in on their commutes. That includes one member of Gov. Spencer...
Author: Sydnee Chapman (Sydnee Chapman)
Tax credit for huge oil producer raises questions about Utah board’s transparency
The following story was reported by The Utah Investigative Journalism Project in partnership with Salt Lake City Weekly. When Utah officials awarded a tax credit to one of the state’s largest oil companies, at least one member of the voting board knew that environmentalists would make noise about a corporate handout to a multi-billion-dollar company. The...
Garfield County received thousands from opioid settlements. Is it spending the money properly?
The following story was reported by The Utah Investigative Journalism Project in partnership with Utah News Dispatch. Garfield County has received tens of thousands of dollars in opioid settlement money, but a lack of records and conflicting statements from county officials raise questions about whether the county is using the money to plug holes in...
Failure to activate: When Utah officers violate body-cam policies
The following story was supported by the Fund for Investigative Journalism and was reported by The Utah Investigative Journalism Project in partnership with Utah News Dispatch. When a Unified police lieutenant tried to pull body-worn camera footage for a case where the suspect had confessed to arson and attempted homicide, he discovered something curious. The...
Learn how to pitch a journalist at free webinar
The Utah Investigative Journalism Project is hosting a free webinar about how to pitch stories to journalists. The event will be on Wednesday, Oct. 22, at 6-7 p.m. Come get your questions answered about what makes a good story pitch and what you can expect from the reporting process from a panel of local journalists....
She begged prosecutors to pursue her sexual assault case. They told a judge she wanted it dismissed
The following story was reported by The Utah Investigative Journalism Project in partnership with Utah News Dispatch. Ann didn’t immediately go into the Hurricane City police station. Instead, she waited outside for nearly half an hour, trying to build up enough courage to walk inside. She was grappling with the decision of whether or not...
Man claims Sandy landlord ignored the mold that was damaging his health
The following story was reported by The Utah Investigative Journalism Project in partnership with Salt Lake City Weekly. Jonathan Rodriguez started noticing small issues after moving into the Legends at River Oaks apartment complex in Sandy: a musty smell; a bit of mold in the toilet; and the fact that his cat, Toby, went from...
Crime victims often left in the dark; improvements may be in works to shed light on developments
The following story was reported by The Utah Investigative Journalism Project in partnership with KSL.com. PROVO — When “Emily” got the letter from the court about her case, it was almost too late. The court sent it to an old address she hadn’t used for years since she was a freshman at Brigham Young University....
Utah lawyer among citizens DHS directed to self deport
The following story was reported by The Utah Investigative Journalism Project in partnership with Utah News Dispatch Carlos Trujillo couldn’t sleep despite it being well past midnight. As both an immigrant and an immigration lawyer, Trujillo has been acutely tuned into the volatile nature of the Trump administration’s immigration policies. That night, in the early...
Utah counties are spending opioid settlement cash on policing. Is that the best use?
The following story was reported by The Utah Investigative Journalism Project in partnership with KUER and the Daily Herald. Firearms, ballistic vests, breathalyzers, police vehicles, wages for law enforcement officers — these are some of the ways counties are using the money they received to combat the opioid crisis. Utah counties have taken a combined...